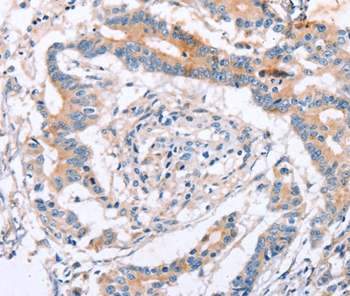

别名:EWI2; PGRL; CD316; EWI-2; KCT-4; CD81P3; LIR-D1应用:IHC
反应种属:Human
规格:50μl/100μl
| Description |
|---|
| This gene encodes a member the EWI subfamily of the immunoglobulin protein superfamily. Members of this family contain a single transmembrane domain, an EWI (Glu-Trp-Ile)-motif and a variable number of immunoglobulin domains. This protein interacts with the tetraspanins CD81 and CD9 and may regulate their role in certain cellular functions including cell migration and viral infection. The encoded protein may also function as a tumor suppressor by inhibiting the proliferation of certain cancers. Alternate splicing results in multiple transcript variants that encode the same protein. |
| Specification | |
|---|---|
| Aliases | EWI2; PGRL; CD316; EWI-2; KCT-4; CD81P3; LIR-D1 |
| Entrez GeneID | 93185; |
| Swissprot | Q969P0 |
| Storage | Store at 4°C short term. Aliquot and store at -20°C long term. Avoid freeze/thaw cycles. |
| Species Reactivity | Human |
| Immunogen | Fusion protein corresponding to a region derived from internal residues of human immunoglobulin superfamily, member 8 |
| Formulation | Rabbit IgG in pH7.4 PBS, 0.05% NaN3, 40% Glycerol. |
| Application | |
|---|---|
| IHC | 1/25-1/100 |
![]() |
Immunohistochemical analysis of paraffin-embedded Human brain tissue using P42771 at dilution 1/15. |
![]() |
Immunohistochemical analysis of paraffin-embedded Human colon cancer tissue using P42771 at dilution 1/15. |
本公司的所有产品仅用于科学研究或者工业应用等非医疗目的,不可用于人类或动物的临床诊断或治疗,非药用,非食用。
暂无评论
本公司的所有产品仅用于科学研究或者工业应用等非医疗目的,不可用于人类或动物的临床诊断或治疗,非药用,非食用。
中文

发表回复